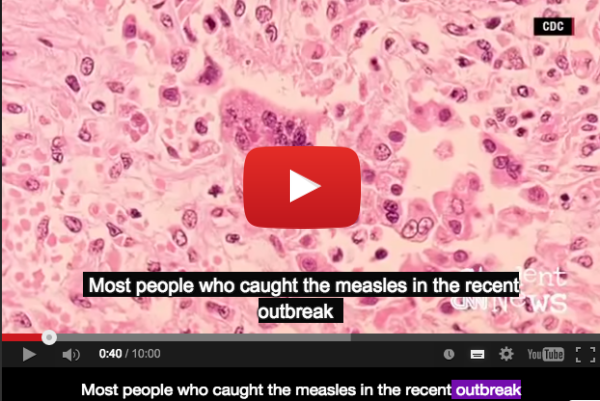
螢幕快照 2015-02-05 下午10.46.02

美國爆發麻疹疫情,接種疫苗的相關議題在政壇引起熱烈討論,
你知道疫苗跟麻疹的英文嗎?還有,要說麻疹議題引起火熱討論,用英文要怎麼說呢?
這次的 CNN 新聞介紹了麻疹爆發及家長不願讓孩子接種疫苗的議題,
而本次的文章除了介紹主題的相關單詞,更為大家整理了字根 out 的用法喔!
↓↓↓點擊以下連結可直接觀看影片↓↓↓
February 4, 2015 – CNN Student News
Vaccine
n. 接種疫苗;痘苗
a. 疫苗的;逗苗的
Seven million doses of vaccine are annually given to British children. 英國的孩童每年接種七百萬劑疫苗。
如果你對各種疫苗的英文名稱,可以參考下面這張疫苗中英文對照表。
那麼,是為了預防怎樣的疾病,才要接種疫苗呢?
本週的影片提到了以下幾種:measles (麻疹)、mumps (腮腺炎)、rubella (德國麻疹)
下面是這幾個單字的相關片語、用法
have measles 出疹子
German measles 德國麻疹
measles pneumonia 麻疹病毒肺炎
has mumps 得了腮腺炎
have rubella 得到德國麻疹
像前面提到的,麻疹問題引起了很大的討論,那麼要怎麼形容火熱的討論呢?
↓↓↓點擊以下連結可直接觀看影片↓↓↓
February 4, 2015 – CNN Student News
heated conversation
這可能是你不太熟悉的用法,所以說,多看 CNN 新聞,絕對可以增加英語力。
這邊的 heated conversation 代表很火熱的討論,如果有某件事情很有爭議性引起很大的討論,就可以說是 a heated argument.
那麼,conversation 這個字還能搭配什麼形容詞呢?
正向的:animated, enjoyable, fascinating, meaningful, in-depth, riveting, hilarious, memorable
負面的:frustrating, one-way, pointless, predictable, lengthy, boring
接著來看看,疫情爆發的英文怎麼說吧!
↓↓↓點擊以下連結可直接觀看影片↓↓↓
February 4, 2015 – CNN Student News
Outbreak
Outbreak
n. 爆發(用在形容戰爭;疾病)
v. 爆發
the outbreak of a flu epidemic 流感的爆發
注意,outbreak後面的介詞要用 of ,後面加上爆發的事物名詞,例如: the outbreak of the war。
另外我們可以來看看這個字的字根「out」,有「go beyond, surpass, exceed」等含義,有「超過;過度;外面;出去」等意涵。
那就讓我們看看其他以 out 為字根的單字吧!
- outdoor 室外的, 戶外的, 野外的 ( out 出去, 外面 +door門→ adj. 室外的, 戶外的, 野外的)
- outer 外部的, 外面的 (out 出去, 外面+er→ adj. 外部的,外面的 )
- outgoing 外向的 (out 出去, 外面+going 走→走出来→外向的)
- outward 向外,在外 (out 出去,外面+ ward 方向→ 向外的)
- out 出外;在外 (out 出去,外面→adv. 出外;在外 v.公布)
- outside 在外面 (out 出去,外面+side 旁邊→ 在外面)
- outwork 戶外工作 (out 出去,外面+work 工作→戶外工作)
- outbreak 爆發 (out 出去,外面+break 中斷→事情中斷→爆發)
- outlaw 歹徒 (out 超過,過度+ law 法律→超越法律之人)
- outwear 穿破 (out 超過,過度+wear 穿→穿出了「洞」)
- outwork 在工作上勝過 (out 出去,外面+work工作→在工作上勝過)
- outflow 流出 (out出去, 外面+flow流→流出)
作者:Blair
Source: ICIBA、ROC Taiwan government、Answers.com
迫不及待想馬上開始練習嗎?
快打開 VoiceTube App 練英文!
✦ 立即下載 >>> https://bit.ly/myenglishissogood
英文單字不要硬背! 藉由 VoiceTube App 看影片,不會的單字反覆聆聽,加上單字測驗練習,聽寫齊下,立刻熟記!





